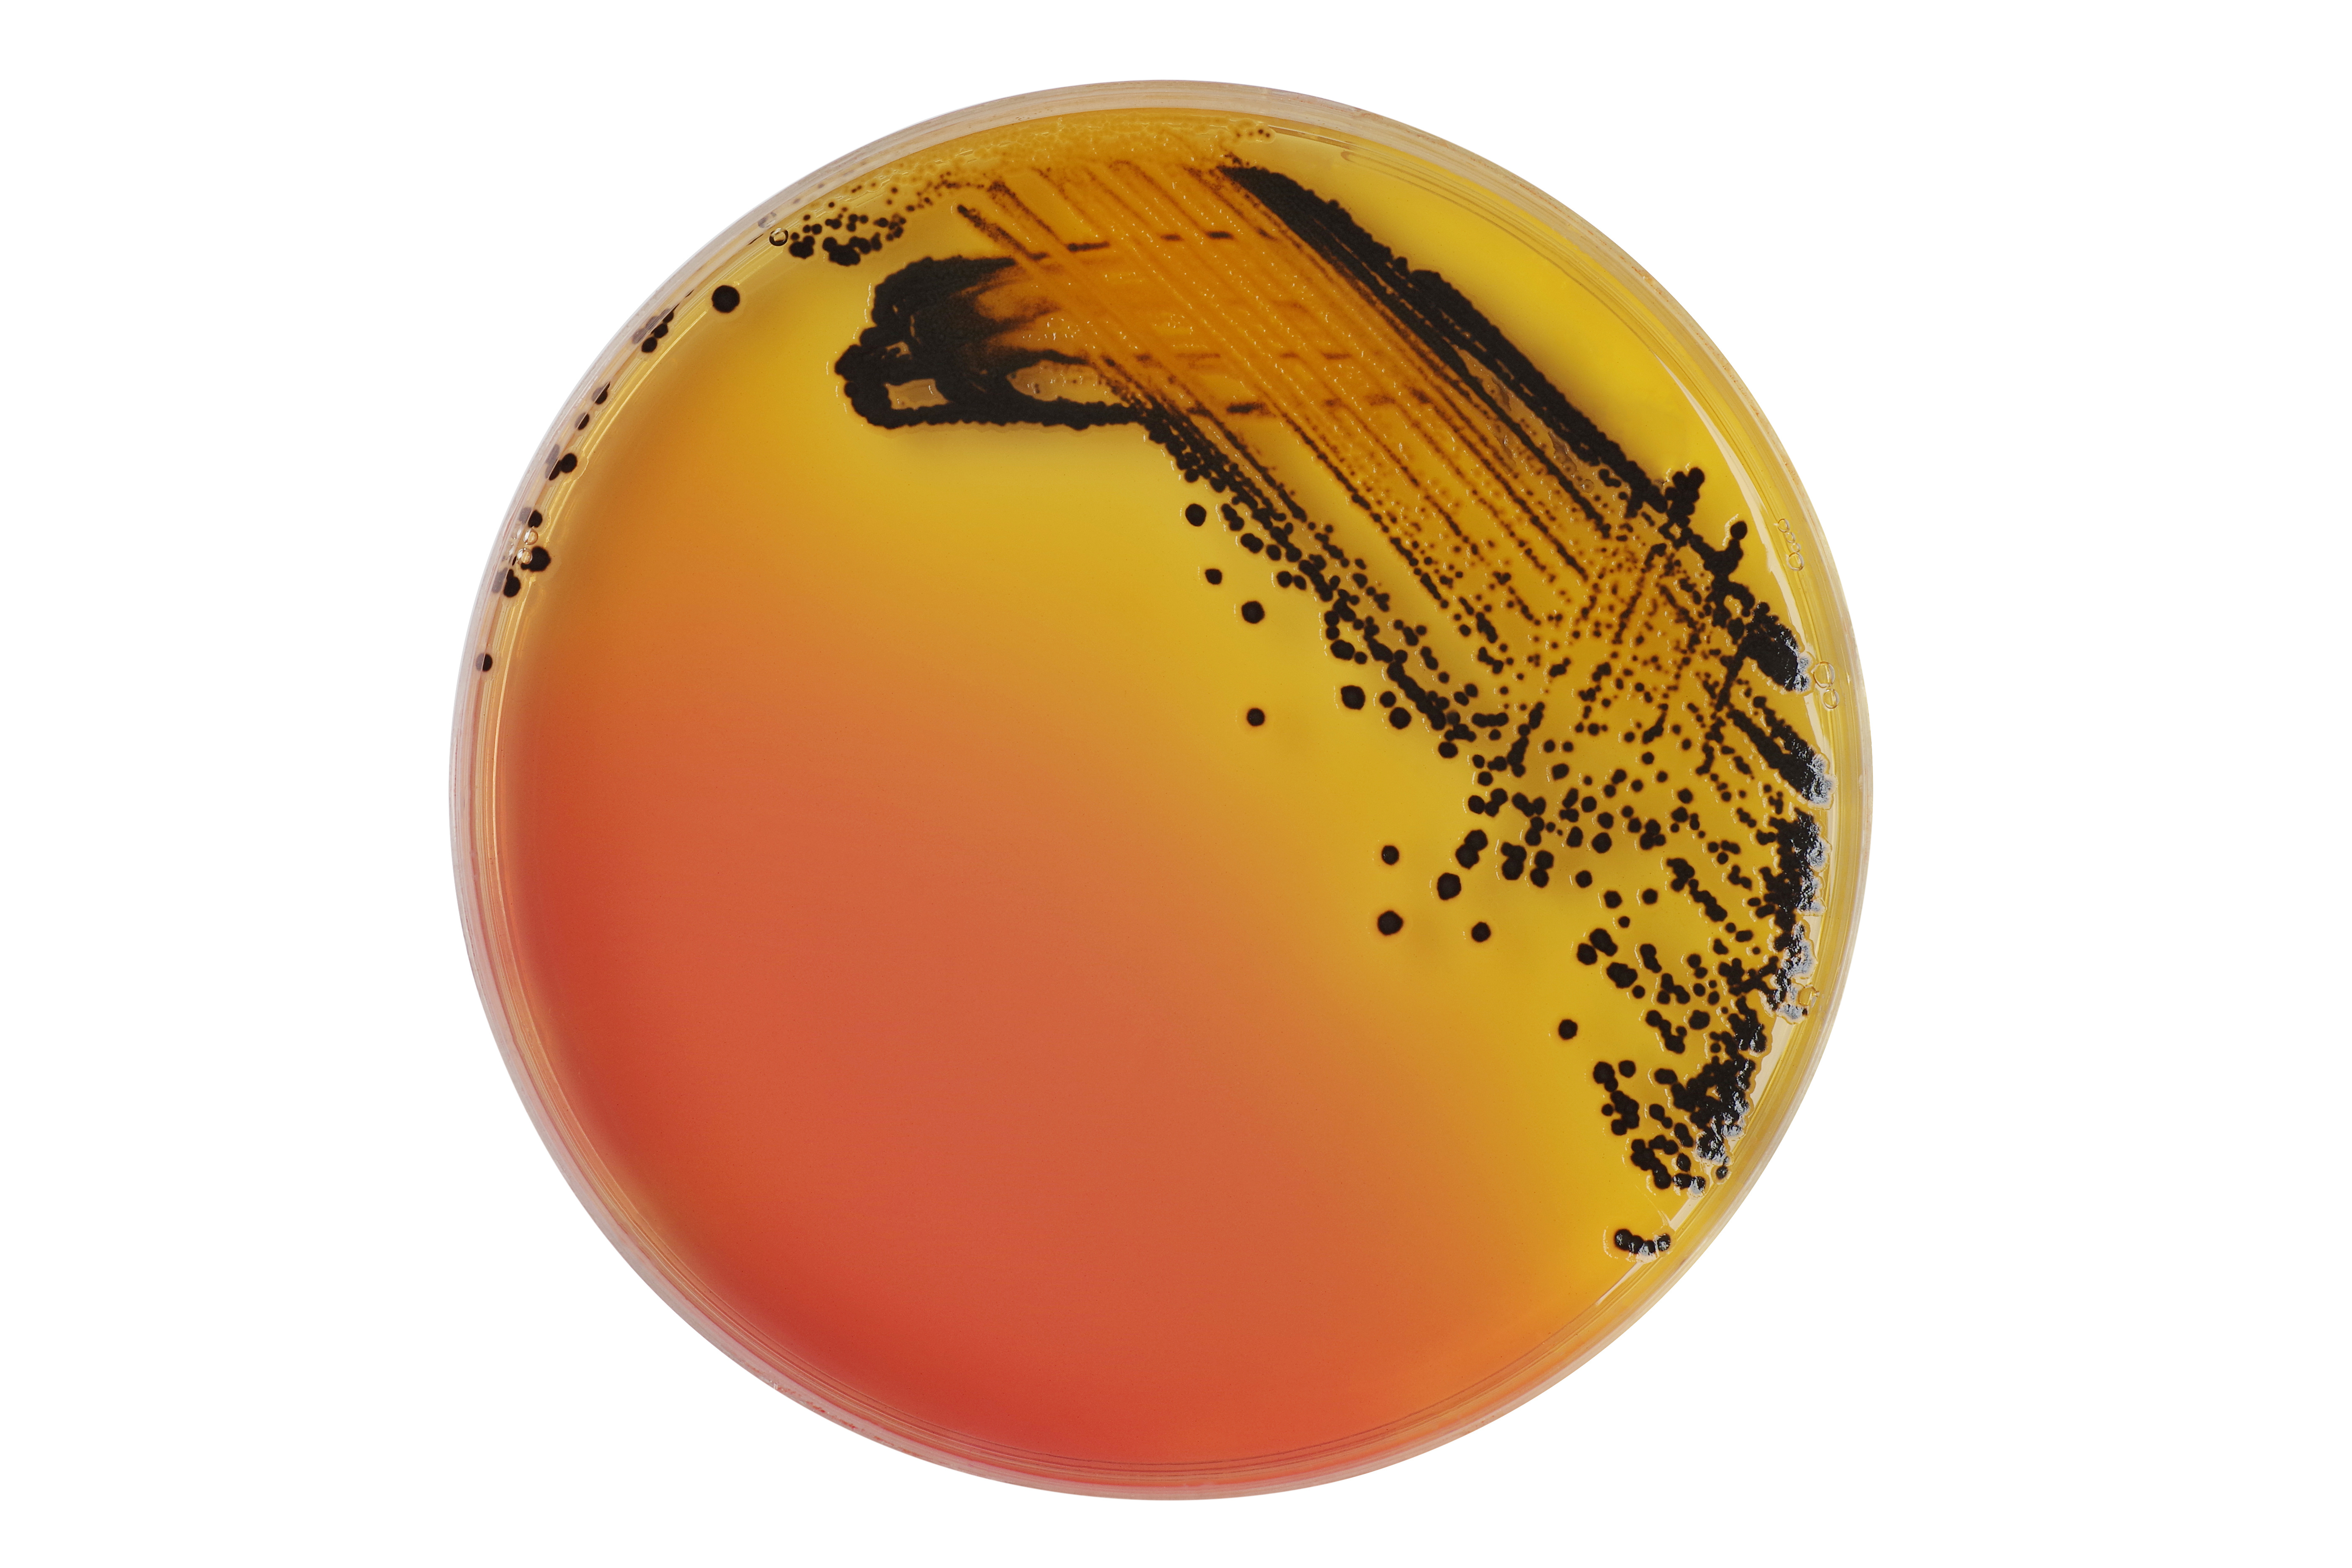

ECT Water Microbiology offers professional, Salmonella test services, accurately detecting low levels of Salmonella in water and environmental samples for a wide range of industries.
Importance of Salmonella Tests
Salmonella infection (salmonellosis) is a common bacterial disease caused by the bacteria Salmonella. It is usually characterised by acute onset fever, abdominal pain, diarrhoea, nausea, and vomiting. Most healthy people will recover within a few days to a week without specific treatment. However, in some cases, it can cause life-threatening complications.
Salmonella bacteria naturally occur in the intestines of animals, including birds, reptiles, livestock, and humans. People are most likely to become infected through contaminated food or water.
While salmonellosis has traditionally been attributed to animal origin, such as meat, eggs, and other poultry products, the number of outbreaks caused by domestic or imported fresh fruits, vegetables, nuts, and spices has been increasing. A recent report from the Centers for Disease Control and Prevention (CDC) suggested nearly half of foodborne illnesses and 23% of deaths were associated with produce consumption.
Our Salmonella Test Services
At ECT Water Microbiology, we provide professional Salmonella test services to accurately identify the presence of Salmonella species in water and environmental samples and prevent outbreaks of disease.
Because Salmonella bacteria are often found in low numbers and need very few viable cells to cause disease, we employ a medium containing novel Inhibigen technology and chromogens. This method reduces background flora, optimising selectivity for clear, precise results.
Our experienced microbiology laboratory team offers accredited testing, maintaining the highest standards and service to provide efficient, reliable results. With our expertise and vast knowledge base, we can assist with any queries you may have.

Why Choose ECT Water Microbiology for Salmonella Test Services?
- Dedicated microbiology & chemistry testing services
- 24 drop-off locations across the UK & Ireland
- Purpose-built, high-capacity laboratory
- Highly experienced team
- Secure & compliant sample handling
- Efficient testing
- Reliable, accurate results
- 24/7 access to reports & data with the LabTrac app













